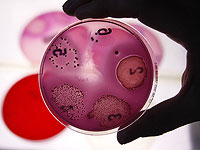
Израильские ученые описали новый механизм, который используют бактерии для защиты от антибиотиков

ВСЕ НОВОСТИ
adv_09 rimma_dw_d
adv_10 rimma_dw_m
adv_11 ca_instrip_direct
adv_12 ca_instrip_direct
adv_12 ca_instrip_direct
adv_12 ca_instrip_direct
adv_12 ca_instrip_direct
adv_12 ca_instrip_direct
adv_12 ca_instrip_direct
adv_12 ca_instrip_direct
ВСЕ НОВОСТИ ::
7 Апреля 2025 г.